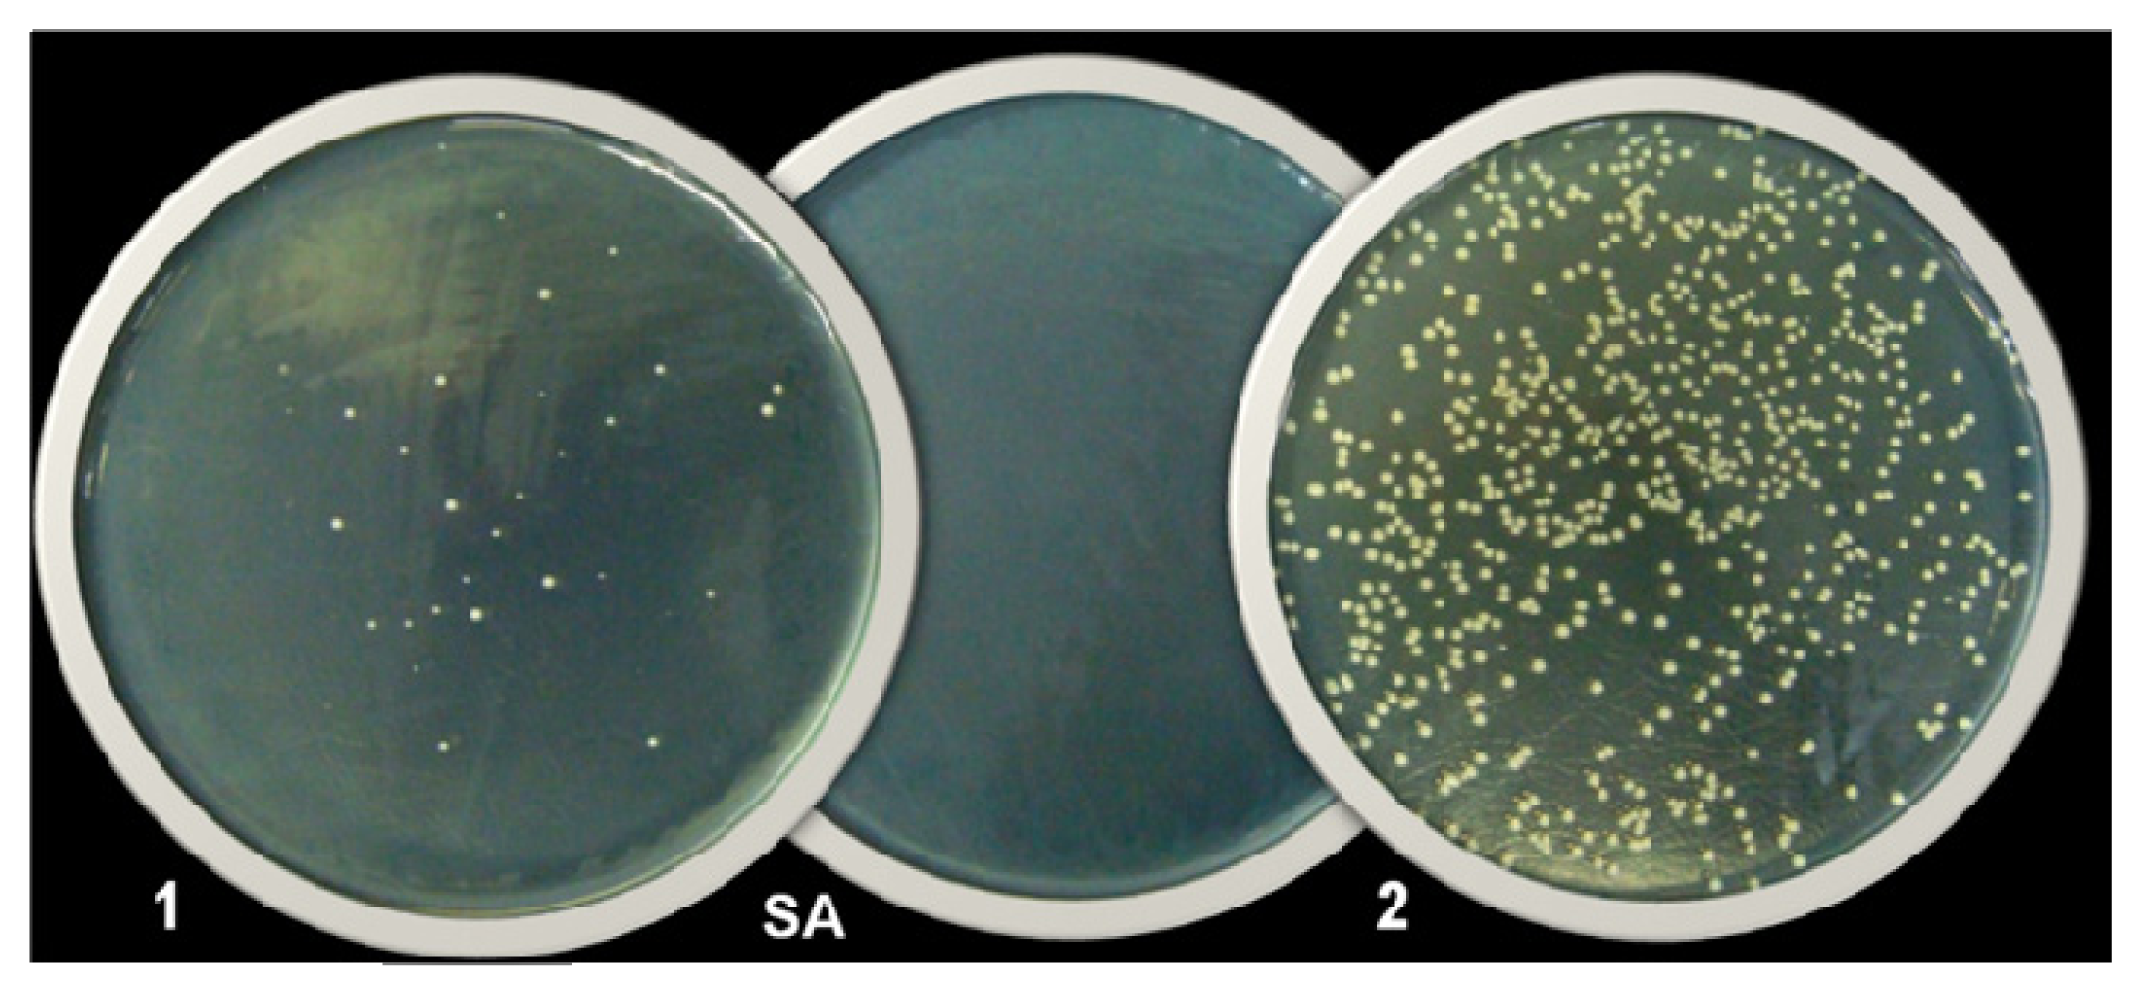
Ijms 14 04969f2 1024

Development and Antibacterial Activity of Cashew Gum-Based Silver Nanoparticles
Abstract
:1. Introduction
2. Results and Discussion
3. Experimental Section
3.1. Cashew Gum Purification
3.2. Synthesis and Characterization of Silver Nanoparticles
3.3. Evaluation of Antibacterial Activity of AgNPs
Determination of the Minimum Inhibitory Concentration (MIC) and Minimum Bactericidal Concentration (MBC) of AgNPs
3.4. Evaluation of Cytotoxicity of AgNPs
4. Conclusions
Acknowledgments
References
- Nicaido, H. Multidrug resistance in bacteria. Ann. Rev. Biochem 2009, 78, 119–146. [Google Scholar]
- Guimarães, D.O.; Momesso, L.S.; Pupo, M.T. Antibióticos: Importância terapêutica e perspectivas para a descoberta e desenvolvimento de novos agentes. Quim. Nova 2010, 33, 667–679. [Google Scholar]
- Huh, A.E.; Kwon, Y.J. “Nanoantibiotics”: A new paradigm for treating infectious diseases using nanomaterials in the antibiotics resistant era. J. Control. Release 2011, 156, 128–145. [Google Scholar]
- Mohanty, S.; Mishra, S.; Jena, P.; Jacob, B.; Sarkar, B.; Sonawane, A. An investigation on the antibacterial, cytotoxic, and antibiofilm efficacy of starch-stabilized silver nanoparticles. Nanomedicine 2012, 8, 916–924. [Google Scholar]
- Fang, M.; Chen, J.; Xub, X.; Yang, P.; Hildebrand, H.F. Antibacterial activities of inorganic agents on six bacteria associated with oral infections by two susceptibility tests. Int. J. Antimicrob. Agents 2006, 27, 513–517. [Google Scholar]
- Allaker, R.P. The use of nanoparticles to control oral biofilm formation. J. Dent. Res 2010, 89, 1175–1186. [Google Scholar]
- Dorjnamjin, D.; Ariunaa, M.; Shim, Y.K. Synthesis of silver nanoparticles using hydroxyl functionalized ionic liquids and their antimicrobial activity. Int. J. Mol. Sci 2008, 9, 807–820. [Google Scholar]
- Rai, M.; Yadav, A.; Gade, A.S. Silver nanoparticles as a new generation of antimicrobials. Biotechnol. Adv 2009, 27, 76–83. [Google Scholar]
- Chaloupka, K.; Malam, Y.; Seifalian, A.M. Nanosilver as a new generation of nanoproduct in biomedical applications. Trends Biotechnol 2010, 28, 580–588. [Google Scholar]
- Kora, A.J.; Sashidhar, R.B.; Arunachalam, J. Gum kondagogu (Cochlospermum gossypium): A template for the green synthesis and stabilization of silver nanoparticles with antibacterial application. Carbohydr. Polym 2010, 82, 670–679. [Google Scholar]
- Shukla, M.K.; Singh, R.P.; Reddy, C.R.K.; Bhavanath, J. Synthesis and characterization of agar-based silver nanoparticles and nanocomposite film with antibacterial applications. Bioresour. Technol 2012, 107, 295–300. [Google Scholar]
- Sharma, K.V.; Yngard, R.A.; Lin, Y. Silver nanoparticles: Green synthesis and their antimicrobial activities. Adv. Colloid Interface Sci 2009, 145, 83–96. [Google Scholar]
- Parashar, U.K.; Kumar, V.; Bera, T.; Saxena, P.S.; Nath, G.; Srivastava, S.K.; Giri, R.; Srivastava, A. Study of mechanism of enhanced antibacterial activity by green synthesis of silver nanoparticles. Nanotechnology 2011, 22. [Google Scholar] [CrossRef]
- Shameli, K.; Ahmad, M.B.; Jazayeri, S.D.; Sedaghat, S.; Shabanzadeh, P.; Jahangirian, H.; Mahdavi, M.; Abdollahi, I. Synthesis and characterization of polyethylene glycol mediated silver nanoparticles by the Green method. Int. J. Mol. Sci 2012, 13, 6639–6650. [Google Scholar]
- Sastri, M.; Ahmad, A.; Khan, M.I.; Kumar, R. Biosynthesis of metal nanoparticles using fungi and actinomycete. Curr. Sci 2003, 85, 162–170. [Google Scholar]
- Shahverdi, A.R.; Fakhimi, A.; Shahverdi, H.R.; Minaian, S. Synthesis and effect of silver nanoparticles on the antibacterial activity of different antibiotics against Staphylococcus aureus and Escherichia coli. Nanomedicine 2007, 3, 168–171. [Google Scholar]
- Fayaz, M.H.; Balaji, K.; Girilal, M.; Yadav, R.; Kalaichelvan, P.H.; Venketesan, R. Biogenic synthesis of silver nanoparticles and their synergistic effect with antibiotics: A study against Gram-positive and Gram-negative bacteria. Nanomedicine 2010, 6, 103–109. [Google Scholar]
- Wei, D.; Sun, W.; Qian, W.; Ye, Y.; Mac, X. The synthesis of chitosan-based silver nanoparticles and their antibacterial activity. Carbohydr. Res 2009, 344, 2375–2382. [Google Scholar]
- Tran, V.V.; Tran, L.D.; Cham, T.B.; Vu, H.D.; Nguyen, T.N.; Pham, D.G.; Nguyen, P.X. Synthesis, characterization, antibacterial and antiproliferative activities of monodisperse chitosan-based silver nanoparticles. Colloids Surf. A 2010, 360, 32–40. [Google Scholar]
- Krishnaraj, C.; Jagan, E.G.; Rajasekar, S.; Selvakumar, P.; Kalaichelvan, P.T.; Mohan, N. Synthesis of silver nanoparticles using Acalypha indica leaf extracts and its antibacterial activity against water borne pathogens. Colloids Surf. B 2010, 76, 50–56. [Google Scholar]
- Saxena, A.; Tripathi, R.M.; Zafar, F.; Singh, P. Green synthesis of silver nanoparticles using aqueous solution of Ficus benghalensis leaf extract and characterization of their antibacterial activity. Mater. Lett 2012, 67, 91–94. [Google Scholar]
- Venkatpurwar, V.; Pokharkar, V. Green synthesis of silver nanoparticles using marine polysaccharide: Study of in-vitro antibacterial activity. Mater. Lett 2011, 65, 999–1002. [Google Scholar]
- De Paula, R.C.M.; Healthy, F.; Budd, P.M. Characterisation of Anacardium occidentale: Exudate polysaccharide. Polym. Int 1998, 45, 27–35. [Google Scholar]
- Mohan, Y.M.; Raju, K.M.; Sambasivudu, K.; Singh, S.; Sreedhar, B. Preparation of Acacia-stabilized silver nanoparticles: A green approach. J. Appl. Polym. Sci 2007, 106, 3375–3381. [Google Scholar]
- Abdel-Mohsen, A.M.; Hrdina, R.; Burgert, L.; Krylova, G.; Abdel-Rahman, R.M.; Krejcova, A.; Steinhart, M.; Benes, L. Green synthesis of hyaluronan fibers with silver nanoparticles. Carbohydr. Polym. 2010. [Google Scholar] [CrossRef]
- Toledo, P.V.M.; Arend, L.N.; Pilonetto, M.; Costa Oliveira, J.C.; Luhm, K.R. Surveillance programme for multidrug-resistant bacteria in healthcare-associated infections: An urban perspective in South Brazil. J. Hosp. Infect 2012, 80, 351–353. [Google Scholar]
- French, G.L. Bactericidal agents in the treatment of MRSA infections-the potential role of daptomycin. J. Antimicrob. Chemother 2006, 58, 1107–1117. [Google Scholar]
- CLSI-Clinical Laboratory Standards Institute. Methods for dilution antimicrobial susceptibility test for bacteria that grow aerobically. Available online: http://www.clsi.org/source/orders/free/m07-a9.pdf accessed on 18 September 2012.
- Chatterjee, A.K.; Sarkar, R.K.; Chattopadhyay, A.P.; Aich, P.; Chakraborty, R.; Basu, T. A simple robust method for synthesis of metallic copper nanoparticles of high antibacterial potency against. E. coli. Nanotechnology 2012, 23. [Google Scholar] [CrossRef]
- Kirkpatrick, C.J. Biological testing of materials and medical devices: A critical view of current and proposed methodologies for biocompatibility testing: Cytotoxicity in vitro. Regulat. Aff 1992, 4, 13–32. [Google Scholar]
- Monteiro, D.R.; Gorup, L.F.; Takamiya, A.S.; Ruvollo-Filho, A.C.; Camargo, E.R.; Barbosa, D.B. The growing importance of materials that prevent microbial adhesion: Antimicrobial effect of medical devices containing silver. Int. J. Antimicrob. Agents 2009, 34, 103–110. [Google Scholar]
- Fontenoy, C.; Kamel, S.O. Silver in the medical devices/equipments: Marketing or real clinical interest? Pharmacien Hospitalier 2010, 45, 131–140. [Google Scholar]
- Silva, D.A.; Feitosa, J.P.A.; Paula, H.C.B.; Paula, R.C.M. Synthesis and characterization of cashew gum/acrylic acid nanoparticles. Mater. Sci. Eng. C 2009, 29, 437–444. [Google Scholar]
- Jevons, M.P. “Celbenin”-resistant staphylococci. Br. Med. J 1961, 1, 124–125. [Google Scholar]

| Bacterial strains | AgNPs | AgNO3 | Antibiotic | ||
|---|---|---|---|---|---|
| MIC | MBC | MIC | MBC | MIC | |
| S. epidermidis | 3.37 | >27 | 3.37 | >27 | Oxacilin |
| ATCC 12228 | <0.5 | ||||
| S. aureus | 13.5 | >27 | 13.5 | >27 | Oxacilin |
| ATCC 29213 | <0.5 | ||||
| S. aureus COL | 13.5 | 13.5 | 13.5 | 13.5 | Vancomycin |
| MRSA | 1 | ||||
| E. faecalis | 13.5 | 27 | 13.5 | >27 | Vancomycin |
| ATCC 29212 | 2 | ||||
| E. coli | 6.75 | 6.75 | 6.75 | 6.75 | Meropenen |
| ATCC 25922 | <0.5 | ||||
| E. coli | 6.75 | 6.75 | 13.5 | 13.5 | Meropenen |
| ATCC 35218 | <0.5 | ||||
| K. pneumoniae | 6.75 | 6.75 | 6.75 | 6.75 | Meropenen |
| ATCC 700603 | <0.5 | ||||
| P.aeruginosa | 3.37 | 6.75 | 6.75 | 6.75 | Meropenen |
| ATCC 27853 | <0.5 | ||||
© 2013 by the authors; licensee MDPI, Basel, Switzerland. This article is an open-access article distributed under the terms and conditions of the Creative Commons Attribution license (http://creativecommons.org/licenses/by/3.0/).
Share and Cite
Quelemes, P.V.; Araruna, F.B.; De Faria, B.E.F.; Kuckelhaus, S.A.S.; Da Silva, D.A.; Mendonça, R.Z.; Eiras, C.; Dos S. Soares, M.J.; Leite, J.R.S.A. Development and Antibacterial Activity of Cashew Gum-Based Silver Nanoparticles. Int. J. Mol. Sci. 2013, 14, 4969-4981. https://doi.org/10.3390/ijms14034969
Quelemes PV, Araruna FB, De Faria BEF, Kuckelhaus SAS, Da Silva DA, Mendonça RZ, Eiras C, Dos S. Soares MJ, Leite JRSA. Development and Antibacterial Activity of Cashew Gum-Based Silver Nanoparticles. International Journal of Molecular Sciences. 2013; 14(3):4969-4981. https://doi.org/10.3390/ijms14034969
Chicago/Turabian StyleQuelemes, Patrick V., Felipe B. Araruna, Bruna E. F. De Faria, Selma A. S. Kuckelhaus, Durcilene A. Da Silva, Ronaldo Z. Mendonça, Carla Eiras, Maria José Dos S. Soares, and José Roberto S. A. Leite. 2013. "Development and Antibacterial Activity of Cashew Gum-Based Silver Nanoparticles" International Journal of Molecular Sciences 14, no. 3: 4969-4981. https://doi.org/10.3390/ijms14034969
APA StyleQuelemes, P. V., Araruna, F. B., De Faria, B. E. F., Kuckelhaus, S. A. S., Da Silva, D. A., Mendonça, R. Z., Eiras, C., Dos S. Soares, M. J., & Leite, J. R. S. A. (2013). Development and Antibacterial Activity of Cashew Gum-Based Silver Nanoparticles. International Journal of Molecular Sciences, 14(3), 4969-4981. https://doi.org/10.3390/ijms14034969

